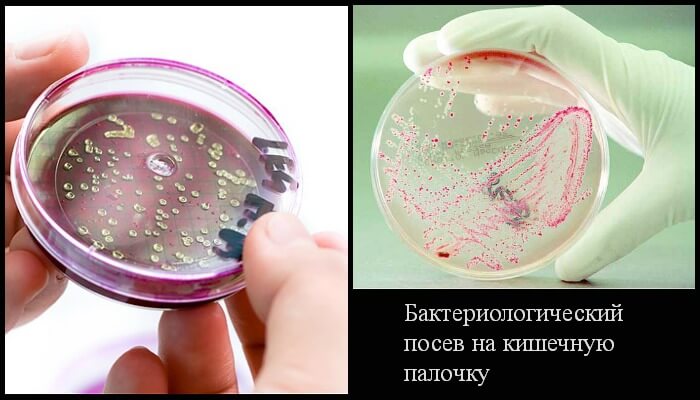
kishka palka

Микробиологи различают около ста штаммов кишечных палочек. Некоторые из них являются непатогенными, то есть такими, которые не вызывают развитие инфекционного заболевания. Более того, такие бактерии являются обязательным компонентом нормальной кишечной микрофлоры. Но есть и патогенные штаммы, их еще называют диареегенными. Это такие штаммы кишечной палочки, которые способны вызвать кишечную, а в некоторых случаях и генерализованную инфекцию.
Патогенные кишечные палочки
Кишечная палочка (Escherichia coli) — бактерии, относящиеся к роду Escherichia и семейству Enterobacteriaceae. Эти микроорганизмы обладают высокой устойчивостью, они способны жить месяцами в воде, почве, фекалиях. Кишечные палочки также способны длительно храниться и даже размножаться в пищевых продуктах, в особенности молочных и мясных.
Патогенные (диареегенные) кишечные палочки в зависимости от их свойств, принято делить на пять основных категорий:
- Энтеротоксигенные (ЭТКП);
- Энтероинвазивные (ЭИКП);
- Энтеропатогенные (ЭПКП);
- Энтерогеморрагические (ЭГКП);
- Энтероаггрегативные (ЭАггКП).
Каждая из этих групп кишечных палочек имеет свои особенности. Так, энтеротоксигенные палочки провоцируют у детей и взрослых холероподобную кишечную инфекцию, поскольку эти бактерии продуцируют токсин, схожий с холерным.
Энтероинвазивные кишечные палочки провоцируют развитие дизентериеподобной кишечной инфекции у детей и взрослых. А энтеропатогенные палочки в отличие от предыдущих штаммов поражают преимущественно детей и вызывают у них развитие коли-энтеритов.
Энтеропатогенные кишечные палочки вызывают развитие геморрагического энтероколита, а энтероаггрегативные — приводят к возникновению кишечной инфекции в основном у ослабленных лиц.
Кишечная палочка, или Escherichia coli, является частью нормальной микрофлоры кишечника человека, однако некоторые штаммы могут вызывать серьезные заболевания. Врачи отмечают, что инфекции, вызванные патогенными штаммами E. coli, могут проявляться в виде диареи, болей в животе и даже более тяжелых состояний, таких как гемолитико-уремический синдром. Основные методы лечения включают поддерживающую терапию, такую как регидратация, и в некоторых случаях применение антибиотиков. Однако врачи подчеркивают, что самолечение может быть опасным, так как неправильное использование антибиотиков может привести к осложнениям и устойчивости бактерий. Профилактика инфекций включает соблюдение правил гигиены и правильную термическую обработку продуктов. Важно обращаться к специалистам при первых симптомах, чтобы избежать серьезных последствий.

Причины
Диареегенные кишечные палочки приводят к развитию инфекционного заболевания под названием эшерихиоз (кишечная коли-инфекция). Для этой инфекции характерны симптомы интоксикации и поражения органов желудочно-кишечного тракта.
Источником инфекции являются больные эшерихиозом, в меньшей мере — бактерионосители. Механизм передачи — фекально-оральный. Человек может заболеть коли-инфекцией при употреблении зараженной пищи (молочных и мясных продуктов, овощей), воды, через грязные руки и предметы ухода, игрушки.
Симптомы эшерихиоза
Эшерехиоз сопровождается симптомами поражения желудочно-кишечного тракта. Однако особенности клинической картины зависят от того, каким именно штаммом инфицирован человек.
Так, эшерихиоз, вызванный энтеротоксигенными палочками, протекает с поражением главным образом тонкой кишки, при этом интоксикация выражена слабо. Заболевание возникает остро с внезапно появившейся слабости, разбитости, головокружения. Температура при этом может быть немного повышенной или даже нормальной. В животе (преимущественно в эпигастрии) возникают разлитые боли схваткообразного характера. Живот вздут, определяется урчание.
У больного появляется диарея, стул обильный, жидкий, который вскоре становится водянистым. Человека могут беспокоить тошнота и многократная рвота. Рвотные массы постепенно становятся жидкими и белесоватыми. На фоне обильной рвоты и диареи развивается дегидратация. Особенности такой клинической картины привели медиков на мысль о схожести болезни с холерой легкой степени. Поэтому эшерихиоз, вызванный энтеротоксигенными палочками, также нередко называют холероподобным.
Эшерихиоз, вызванный энтероинвазивными палочками, вызывает поражение толстого отдела кишечника. Развивается заболевания с возникновения общеинтоксикационных симптомов: слабости, головной боли, озноба, повышения температуры. Спустя несколько часов возникают схваткообразные боли внизу живота. Возникает диарея, стул сначала водянистый и обильный. Но по мере поражения толстой кишки развивается колит. Симптомами этого состояния являются частый жидкий или кашицеобразный стул с примесью слизи, прожилками крови. Этот вариант эшерихиоза характеризуется доброкачественным течением. Температура и стул нормализуются уже спустя один-три дня.
Эшерихиозы, вызванные энтеропатогенными палочками, протекают в виде энтероколитов, а у новорожденных детей (особенно недоношенных) может приобретать системный характер в виде сепсиса. Кишечная форма эшерихиоза характеризуется общеинтоксикационными симптомами, а также рвотой, водянистым стулом желтоватого цвета со слизью. Септическая форма заболевания протекает с гораздо более выраженным интоксикационным синдромом. У малыша сильно повышается температура, он отказывается от кормления, рвет, на коже возникают гнойнички.
Для эшерихиоза, вызванного энтерогеморрагическими палочками, симптомы интоксикации выражены слабо, температура зачастую остается нормальной. На передний план выступают симптомы энтероколита: жидкий водянистый стул до пяти раз в день. Вскоре развивается геморрагический колит, который сопровождается выраженными болями в животе, тенезмами, а также жидким стулом с кровью. Приблизительно у 5% больных спустя неделю развиваются опасные осложнения в виде гемолитико-уремического синдрома, а также тромбоцитопенической пурпуры.
Кишечная палочка, или Escherichia coli, — это бактерия, обитающая в кишечнике человека и животных. Большинство штаммов безвредны и даже полезны, однако некоторые могут вызывать серьезные заболевания. Люди часто обсуждают кишечную палочку в контексте пищевых отравлений, особенно после употребления недоваренного мяса или загрязненных овощей. Симптомы инфекций могут включать диарею, боли в животе и лихорадку. Важно помнить, что лечение зависит от типа штамма и тяжести заболевания. В большинстве случаев достаточно поддерживающей терапии, включая обильное питье и отдых. В более серьезных случаях может потребоваться антибиотикотерапия. Профилактика включает соблюдение правил гигиены и тщательное приготовление пищи.

Кишечная палочка в моче и мазках
При несоблюдении правил личной гигиены, а также во время полового акта кишечная палочка способна проникать во влагалище. В дальнейшем этот микроорганизм провоцирует развитие вагинита и кольпита, а при снижении иммунитета бактерия способна проникнуть в мочевые органы и вызвать их воспаление (цистит, пиелонефрит).
Для диагностирования заболеваний органов мочеполовой системы необходимо произвести бак исследование мочи. Однако наличие кишечных палочек в моче не всегда говорит о наличии заболевания. Бактерии, обнаруженные в малом количестве, могут означать, что женщина перед сдачей анализа не произвела должные гигиенические процедуры. Однако если в анализе мочи определяется не менее 102-104 кишечных палочек при наличии симптомов заболевания, это свидетельствует в пользу воспалительного процесса, протекающего в почках или же мочевом пузыре.
У мужчин именно кишечная палочка часто является причиной простатита, орхита или эпидидимита.
Лечение кишечной палочки
Лечение эшерихиоза должно проводиться в стационаре. Легкие формы инфекции не требуют назначения антибактериальных средств. При среднетяжелых формах коли-инфекции назначают антибиотики из группы фторхинолонов (норфлоксацин, офлоксацин). При тяжелой форме эшерихиоза приписывают препараты из группы цефалоспоринов (цефотаксима), фторхинолонов совместно с аминогликозидами.
Немаловажное значение играет и восстановление нормального водно-электролитного баланса. Так, при отсутствии признаков обезвоживания предпочтение отдают оральным средствам регидратации (регидрон, оралит). При наличии обезвоживания назначают парентеральные инфузионные средства («Ацесоль», «Трисоль» и пр.).
После курса антибиотикотерапии пациентам нередко назначают эубиотики.
Григорова Валерия, медицинский обозреватель

Вопрос-ответ
Как лечится кишечная палочка?
Основа лечения кишечных инфекций в легкой форме – регидратация (восполнение потерянной жидкости тела больного путем приема солевых растворов внутрь) и дезинтоксикационная терапия. Для выведения токсических продуктов возбудителя используются сорбенты, эубиотики, ферменты и вяжущие средств.
Где можно заразиться кишечной палочкой?
Наиболее распространенной инфекцией, вызванной кишечной палочкой (E. Coli), являются инфекции мочевыводящих путей, но у людей также могут развиться кишечные инфекции после употребления зараженной пищи (например недоваренной говядины), контакта с инфицированными животными или употребления зараженной воды.
Что такое кишечная палочка и чем она опасна?
Кише́чная па́лочка (лат. Escherichia coli) — вид грамотрицательных палочковидных бактерий, широко распространённых в нижней части кишечника теплокровных животных. Большинство штаммов E. Coli являются безвредными, однако серотип O157: H7 может вызывать тяжёлые пищевые отравления у людей и животных.
Где можно подхватить кишечную палочку?
Особенно быстро они размножаются в молочных продуктах, мясном фарше, студне, киселе, а также в воде. Летом очень легко подхватить такое заболевание, как дизентерия, потому что переносчиками этой инфекции нередко являются мухи и другие насекомые.
Советы
СОВЕТ №1
Перед тем как начать лечение, обязательно проконсультируйтесь с врачом. Самолечение может усугубить состояние и привести к осложнениям, поэтому важно получить профессиональную помощь и точный диагноз.
СОВЕТ №2
Обратите внимание на гигиену. Регулярное мытье рук, особенно перед едой и после посещения туалета, поможет предотвратить заражение кишечной палочкой и другими инфекциями.
СОВЕТ №3
Следите за качеством продуктов питания. Избегайте употребления сырых или недостаточно термически обработанных продуктов, особенно мяса, молока и яиц, чтобы снизить риск заражения.
СОВЕТ №4
Увлажняйте организм. При кишечной инфекции важно пить много жидкости, чтобы избежать обезвоживания. Вода, электролитные растворы или специальные напитки помогут поддержать водный баланс.